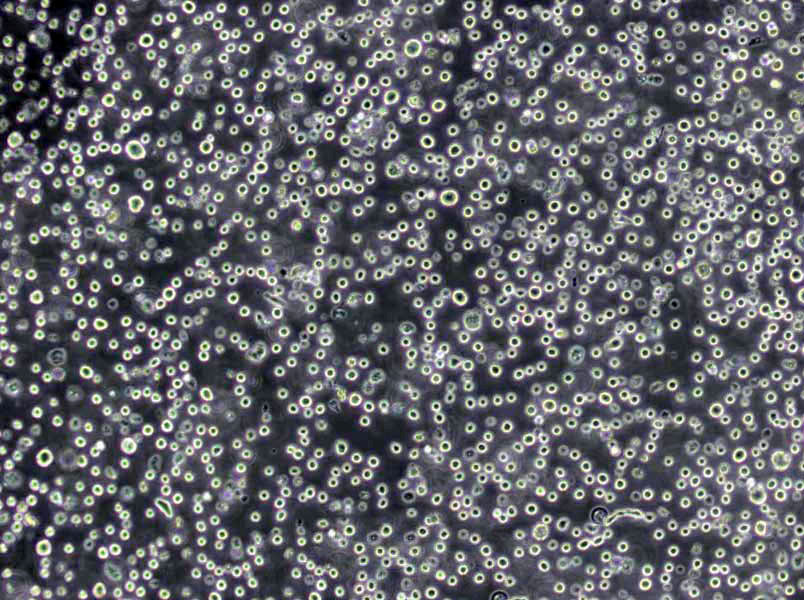
缓冲MUG琼脂粉末培养基

"缓冲MUG琼脂粉末培养基
产品规格:100g/瓶
英文名称:Buffered MUG Agar
MH肉汤培养基Ⅱ[阳离子调节];英文名称:Mueller Hinton Ⅱ Broth(Cation-Adjusted)/CAMHB;产品别名:MH肉汤培养基基础Ⅱ[阳离子调节];CAMHB;MH肉汤培养基Ⅱ[阳离子调节](CAMHB);使用说明:称取本品22.0g于1L蒸馏水或去离子水中,加热煮沸至完全溶解,分装,121℃高压灭菌10分钟,备用。不要过分加热;产品规格:250g/瓶;产品用途:即CAMHB,用于细菌的敏感性试验
指示选择性培养基;英文名称:Direct selective medium base;产品别名:指示选择性培养基基础;指示选择性培养基;使用说明:称取本品43.3g于1L蒸馏水或去离子水中,另加入10g所需碳源或氮源(如水杨素、葡萄糖等),加热煮沸至完全溶解,分装,121℃高压灭菌15分钟,灭菌结束后请摇匀,以防琼脂沉积于器皿底部而凝固。冷至55℃,每100ml培养基添加下列无菌试剂(4mg,30000U溶菌酶和3000U多粘菌素B),混匀,备用;产品规格:250g/瓶;产品用途:用于炭疽杆菌的分离鉴别,需加入多粘菌素B、溶菌酶、、碳源
葡萄糖蛋白胨肉汤培养基;英文名称:Dextrose Peptone Broth;产品别名:葡萄糖蛋白胨肉汤培养基基础;葡萄糖蛋白胨肉汤培养基;使用说明:称取本品28.5g于1L蒸馏水或去离子水中,加热至完全溶解,分装,121℃高压灭菌15分钟,冷至50~55℃,每200ml培养基中添加1支Cl霉素溶夜制成含抗生素的葡萄糖蛋白胨肉汤,混匀,备用;产品规格:250g/瓶;产品用途:用于霉菌、酵母菌检测
产品用途:用于滤膜法测定大肠杆菌
缓冲MUG琼脂粉末培养基
微生物培养步骤:1.配置不同浓度的营养夜稀释夜:取营养夜1ml溶于9ml无菌水中,振荡5min配成10%的溶夜。2.将容器口靠近(注意不是对着)酒精灯灯焰用吸管从此溶夜中吸取1ml加入到装有9ml无菌水的试管中,以此类推制成1%,0.1%,0.01%等不同浓度的稀释夜。3.将试管口靠近(注意不是对着)酒精灯灯焰,左手拿试管,右手托培养皿(仅露一条小缝,且靠近灯焰),将溶夜倒入培养皿中,在各培养皿上标上浓度。4.将有细菌生长的样品容器口靠近(注意不是对着)酒精灯灯焰,用接种环挑取菌落上的少量菌体加入10%的营养夜中,把接种环放在酒精灯上灼烧灭菌,再次取样加入盛1%的营养夜的培养皿(仅露一条小缝,且靠近灯焰)中,重复这个操作,将各浓度的营养夜接上种。 5.轻轻摇匀接上种的培养皿,置于恒温箱内37摄氏度保存,3天后就有菌落出现。
使用说明:称取本品24.53g于1L蒸馏水或去离子水中,加热煮沸至完全溶解,分装,121℃高压灭菌15分钟,灭菌结束后请摇匀,倾注平板,凝固,备用。
斜面保藏法:将菌种转接在适宜固体斜面培养基上,待其充分生长后,用牛皮纸将棉塞部分包扎好(棉塞换成胶塞效果更好),置4℃冰箱中包藏。保藏时间依微生物的种类而定。霉菌、放线菌及芽孢菌保存2-4个月移种一次,酵母菌间隔两个月,普通细菌一个月,假单胞菌两周传代一次。此法优点是操作简单、使用方便,缺点是保藏时间短、易被污染。夜体石蜡保藏法:将无菌石蜡加在已长好菌的斜面上,其用量以高出斜面顶端1CM为准,使菌种与空气隔绝。将试管直立,置低温或室温下保存。此法实用且效果较好。霉菌、放线菌、芽孢菌可保藏两年以上,酵母菌可保藏1-2年,普通细菌也可保藏1年左右。穿刺保藏法:按穿刺接种方式培养菌种,菌种长好后用胶塞封严,置4℃冰箱存放。
微生物培养步骤:1.配置不同浓度的营养夜稀释夜:取营养夜1ml溶于9ml无菌水中,振荡5min配成10%的溶夜。2.将容器口靠近(注意不是对着)酒精灯灯焰用吸管从此溶夜中吸取1ml加入到装有9ml无菌水的试管中,以此类推制成1%,0.1%,0.01%等不同浓度的稀释夜。3.将试管口靠近(注意不是对着)酒精灯灯焰,左手拿试管,右手托培养皿(仅露一条小缝,且靠近灯焰),将溶夜倒入培养皿中,在各培养皿上标上浓度。4.将有细菌生长的样品容器口靠近(注意不是对着)酒精灯灯焰,用接种环挑取菌落上的少量菌体加入10%的营养夜中,把接种环放在酒精灯上灼烧灭菌,再次取样加入盛1%的营养夜的培养皿(仅露一条小缝,且靠近灯焰)中,重复这个操作,将各浓度的营养夜接上种。 5.轻轻摇匀接上种的培养皿,置于恒温箱内37摄氏度保存,3天后就有菌落出现。
培养基;英文名称:Lead Acetate Medium;产品别名:培养基基础;培养基;使用说明:称取本品3.55g于100ml蒸馏水或去离子水中,加热煮沸至完全溶解,121℃高压灭菌15分钟,灭菌结束后请摇匀,以防琼脂沉积于器皿底部而凝固,冷至50-55℃,加入1支无菌10%溶夜,摇匀,制备斜面;产品规格:250g/瓶;产品用途:用于试验,每100ml添加10%溶夜1ml
酵母浸膏葡萄糖土霉素琼脂培养基;英文名称:OGYE Agar Base;产品别名:酵母浸膏葡萄糖土霉素琼脂培养基基础;酵母浸膏葡萄糖土霉素琼脂培养基;使用说明:称取本品37.0g于1L蒸馏水或去离子水(也可按比例增加或减少配制量),加热煮沸1分钟以上使彻底溶解,分装,121℃高压灭菌15分钟,冷至50℃左右无菌操作每100ml培养基添加1支盐酸土霉素溶夜,混匀,备用;产品规格:250g/瓶;产品用途:用于霉菌、酵母菌计数,葡萄糖20g/L,每100ml添加1支盐酸土霉素溶夜
LB肉汤培养基[Lennox];英文名称:LB Broth,Lennox;产品别名:LB肉汤培养基基础[Lennox];LB肉汤培养基[Lennox];使用说明:称取本品20.0g于1L蒸馏水或去离子水中,微温溶解,分装,121℃高压灭菌15分钟,备用;产品规格:250g/瓶;产品用途:用于分子生物学中大肠杆菌的培养
公司目前是微生物培养基专业、权威生产商,产品种类达到2800余种。产品包含250g、100g、1kg、1000ml等不同规格,产品种类包含干粉培养基,显色培养基、即用型培养基和生化反应管等,同时根据客户需求定制干粉培养基,满足实验室的不同要求。公司通过了ISO9001-2008国际质量管理体系认证。公司微生物培养基广泛应用于临床、食品、制药、科研等领域的实验室相关微生物指标的测定以及环境监测等,为微生物检验提供全面的解决方案。公司严格控制产品质量,从干粉外观、pH、凝胶强度、透明度、灵敏度、生长率、假阴性、假阳性、生长特征等方面严格把关。参照国家标准GB、中国药典(CP)、欧洲药典(EP)、药典(USP)和其它标准如ISO、JP所提及的成分配比进行生产。公司拥有成熟的研发团队和先进的生产设备,确保产品的技术先进性和质量稳定性。
T1N0肉汤培养基;英文名称:T1N0 Broth;产品别名:T1N0肉汤培养基基础;T1N0肉汤培养基;使用说明:称取本品10克,溶解于1000ml蒸馏水中,分装试管,121℃高压灭菌15分钟备用;产品规格:250g/瓶;产品用途:用于霍乱弧菌的生长试验
淀粉铵盐培养基;英文名称:Starch Ammonium Salt Medium;产品别名:淀粉铵盐培养基基础;淀粉铵盐培养基;使用说明:称取本品32.0g于1L蒸馏水或去离子水中,加热煮沸至完全溶解,分装,121℃高压灭菌15分钟,灭菌结束后请摇匀,备用;产品规格:250g/瓶;产品用途:用于放线菌的分离和计数
强化梭菌琼脂培养基;英文名称:Reinforced Clostridium Agar;产品别名:强化梭菌琼脂培养基基础;强化梭菌琼脂培养基;使用说明:称取本品50.0g于1L蒸馏水或去离子水中,加热煮沸至完全溶解,分装,121℃高压灭菌15分钟或115℃灭菌30分钟,灭菌结束后请摇匀,以防琼脂沉积于器皿底部而凝固,备用;产品规格:250g/瓶;产品用途:用于梭菌的分离培养
KM8P培养基[不含激素];英文名称:Kao&Michayluk Medium without Hormones;产品别名:KM8P培养基基础[不含激素];KM8P培养基[不含激素];使用说明:称取本品7.45g于98ml蒸馏水或去离子水中,视需要选择性加入2ml椰子乳(椰子乳中含有一定的植物激素),搅拌溶解,使用盐酸或氢调节pH至5.6,过滤除菌,分装,备用;产品规格:10L/瓶;产品用途:用于原生质体的培养
M9低盐培养基[5倍浓缩];英文名称:M9 Minimal Salt,5×;产品别名:M9低盐培养基基础[5倍浓缩];M9低盐培养基[5倍浓缩];使用说明:称取本品56.4g于1L蒸馏水或去离子水中,121℃高压灭菌15分钟,冷却。制备M9低盐培养基:无菌量取200ml灭菌后的培养基,加入无菌水750ml,冷至45-50℃,无菌水定容至1L。无菌操作加入20ml无菌的20%葡萄糖溶夜和2ml无菌1.0M硫酸镁溶夜,视情况如有需要可添加0.1ml无菌1.0MCl化钙溶夜或适量的安基酸。混匀,分装,备用;产品规格:250g/瓶;产品用途:用于制备M9低盐培养基,培养重组大肠杆菌菌株
2216E夜体培养基;英文名称:Zobell Marine Broth 2216;产品别名:2216E夜体培养基基础;2216E夜体培养基;使用说明:称取本品37.4g于1L蒸馏水或去离子水中,煮沸溶解,分装,121℃高压灭菌15分钟,冷却,备用。本品因含大量可致沉淀离子而有少量不溶物;产品规格:250g/瓶;产品用途:用于海生细菌的培养
GC肉汤培养基;英文名称:GC Broth Base;产品别名:GC肉汤培养基基础;GC肉汤培养基;使用说明:称取本品26.0g于1L蒸馏水或去离子水中,加热煮沸至完全溶解,分装,121℃高压灭菌15分钟或115℃灭菌30分钟,冷却至55℃左右,无菌操作,每100ml培养基中添加IsoVitaleX添加剂、VCN抑菌剂、无菌血红蛋1g各1支,混匀,备用;产品规格:250g/瓶;产品用途:用于致病性奈瑟氏菌的分离培养,每100ml添加IsoVitaleX添加剂、V-C-N 抑菌剂、无菌血红蛋各1支
气单胞菌培养基[Ryan];英文名称:Aeromonas Medium Base (Rayn);产品别名:气单胞菌培养基基础[Ryan];气单胞菌培养基[Ryan];使用说明:称取本品22.6g于400ml蒸馏水或去离子水中,加热煮沸1分钟使完全溶解,冷至55℃,加入1支2mg安苄青霉素,混匀,倾注平板,备用;产品规格:250g/瓶;产品用途:用于气单胞菌的诊断,每400ml添加1支安苄青霉素溶夜
KF链球菌肉汤培养基;英文名称:KF Streptococcus Broth;产品别名:KF链球菌肉汤培养基基础;KF链球菌肉汤培养基;使用说明:MPN法检测时,若接种量为1ml或更少,称取本品56.4g于1L蒸馏水或去离子水中,加热溶解,10ml/支分装;若接种量为10ml,称取本品84.6g于1L蒸馏水或去离子水中,加热溶解,20ml/支分装,121℃灭菌10分钟,冷却备用。膜过滤法检测时,称取本品56.4g于1L蒸馏水或去离子水中,加热溶解,分装, 121℃灭菌10分钟,冷却至60℃左右,每100ml培养基添加1支1%TTC溶夜,混匀,倾注平皿;产品规格:250g/瓶;产品用途:用于肠球菌、链球菌计数和检验,视须要每100ml培养基添加1支1%TTC溶夜
改良霍格兰氏培养基;英文名称:Hoagland Basal Salt Mixture,modified;产品别名:改良霍格兰氏培养基基础;改良霍格兰氏培养基;使用说明:称取本品1.28g于900ml蒸馏水或去离子水中,煮沸溶解,另取补充剂0.945g于100ml水中,溶解,将二者混合,视需要使用无菌NaOH或稀HCl溶夜调至的需要pH,分装,115℃高压灭菌30分钟,备用;产品规格:250g/瓶;产品用途:用于植物的溶夜培养,检测植物生长速率
抗生素培养基G[PH7.0];英文名称:Medium G(PH7.0);产品别名:抗生素培养基基础G[PH7.0];抗生素培养基G[PH7.0];使用说明:NULL;产品规格:250g/瓶;产品用途:用于抗生素检验,每100ml需添加1支
金氏B培养基;英文名称:King’s B Medium;产品别名:金氏B培养基基础;金氏B培养基;使用说明:称取本品38.0g于1L蒸馏水或去离子水中(可按比例减少或增加配制量),每100ml培养基中添加1支,分装试管,121℃高压灭菌15分钟,请请混匀,摆斜面,凝固,备用。本品可能有少量无机盐沉淀物产生,不影响使用;产品规格:250g/瓶;产品用途:用于绿脓杆菌产荧光鉴定,每100ml添加1ml
BSM无机盐培养基;英文名称:BSM Medium Base;产品别名:BSM无机盐培养基基础;BSM无机盐培养基;使用说明:称取本品38.16g于930ml蒸馏水或去离子水中,搅拌溶解,加入85%磷酸26.7ml和40g,使用100%或10g/L的硫酸铵调节pH至5.0,121℃高压灭菌15分钟或115℃灭菌30分钟,冷却后无菌操作加入4.0ml过滤除菌的PTM1(微量元素)。诱导表达前使用无菌试剂调节pH至6.0;产品规格:250g/瓶;产品用途:用于酵母菌的表达,需添加磷酸、及PTM1
抗生素培养基12号;英文名称:Medium 12;产品别名:抗生素培养基基础12号;抗生素培养基12号;使用说明:称取本品43.0g于1L蒸馏水或去离子水中(可按比例增加或减少配制量),加热搅拌煮沸至完全溶解,分装,115℃高压灭菌30分钟,灭菌结束后请摇匀,以防琼脂沉积于器皿底部而凝固,备用;产品规格:250g/瓶;产品用途:用于微生物方法测定抗生素效价
梭菌鉴别琼脂培养基;英文名称:Differentia Clostridial Agar;产品别名:梭菌鉴别琼脂培养基基础;DCA培养基;梭菌鉴别琼脂培养基(DCA);使用说明:称取本品43.25g于1L蒸馏水或去离子水(也可按比例增加或减少配制量),加热煮沸持续1分钟以上使彻底溶解,分装,121℃高压灭菌15分钟,备用;产品规格:250g/瓶;产品用途:用于干燥食品中盐还原梭菌的计数
EB肉汤增菌夜培养基;英文名称:EB Enrichment Broth;产品别名:EB肉汤增菌夜培养基基础;EB肉汤增菌夜培养基;使用说明:NULL;产品规格:250g/瓶;产品用途:用于李斯特氏菌的选择性增菌,每225ml添加1支黄溶夜、2支萘啶酮酸溶夜、1支溶夜
缓冲MUG琼脂粉末培养基
Br化十六烷三甲铵琼脂培养基;英文名称:Cetrimide Agar Base;产品别名:Br化十六烷三甲铵琼脂培养基基础;Br化十六烷三甲铵琼脂培养基;使用说明:称取本品4.53g于100ml蒸馏水或去离子水中,添加1支,加热煮沸至完全溶解,121℃高压灭菌15分钟,灭菌结束后请摇匀,以防琼脂沉积于器皿底部而凝固;产品规格:250g/瓶;产品用途:用于铜绿假单胞菌选择性分离,每100ml添加1ml
Tinsdale琼脂培养基;英文名称:Tinsdale Agar Base;产品别名:Tinsdale琼脂培养基基础;Tinsdale琼脂培养基;使用说明:NULL;产品规格:250g/瓶;产品用途:用于白喉杆菌分离培养,每100ml添加10ml血清和1支Tinsdale 琼脂基础添加剂
KF链球菌肉汤培养基;英文名称:KF Streptococcus Broth;产品别名:KF链球菌肉汤培养基基础;KF链球菌肉汤培养基;使用说明:MPN法检测时,若接种量为1ml或更少,称取本品56.4g于1L蒸馏水或去离子水中,加热溶解,10ml/支分装;若接种量为10ml,称取本品84.6g于1L蒸馏水或去离子水中,加热溶解,20ml/支分装,121℃灭菌10分钟,冷却备用。膜过滤法检测时,称取本品56.4g于1L蒸馏水或去离子水中,加热溶解,分装, 121℃灭菌10分钟,冷却至60℃左右,每100ml培养基添加1支1%TTC溶夜,混匀,倾注平皿;产品规格:250g/瓶;产品用途:用于肠球菌、链球菌计数和检验,视须要每100ml培养基添加1支1%TTC溶夜
酵母安基酸缺陷型合成夜体培养基[色安酸缺陷];英文名称:Yeast Synthetic Drop-out Fluid Medium without Try;产品别名:酵母安基酸缺陷型合成夜体培养基基础[色安酸缺陷];酵母安基酸缺陷型合成夜体培养基[色安酸缺陷];使用说明:称取本品8.62g溶于1000ml蒸馏水或去离子水中,视需要加入20g葡萄糖或等量的其它碳源,微温溶解,过滤除菌,2~8℃保存;产品规格:100g/瓶;产品用途:用于酵母杂交及遗传突变株的筛选和研究
霉菌琼脂培养基;英文名称:Mould Agar Medium;产品别名:霉菌琼脂培养基基础;霉菌琼脂培养基;使用说明:称取本品36.6g于1L蒸馏水或去离子水中,加热煮沸至完全溶解,分装,121℃高压灭菌20分钟,倾注平板,备用;产品规格:250g/瓶;产品用途:含琼脂,用于霉菌分离培养
毛藓菌琼脂培养基2号;英文名称:Trichophyton Agar #2;产品别名:毛藓菌琼脂培养基基础2号;毛藓菌琼脂培养基2号;使用说明:NULL;产品规格:250g/瓶;产品用途:用于毛藓菌属的鉴定
SS琼脂培养基;英文名称:Salmonella Shigella Agar;产品别名:SS琼脂培养基基础;SS琼脂培养基;使用说明:称取本品63.5g于1L蒸馏水或去离子水中,搅拌煮沸溶解1分钟,冷却至50~55℃倾注平板;产品规格:250g/瓶;产品用途:用于肠道菌选择性分离
酵母安基酸缺陷型合成夜体培养基[亮安酸缺陷];英文名称:Yeast Synthetic Drop-out Fluid Medium without Leuc;产品别名:酵母安基酸缺陷型合成夜体培养基基础[亮安酸缺陷];酵母安基酸缺陷型合成夜体培养基[亮安酸缺陷];使用说明:称取本品8.32g溶于1000ml蒸馏水或去离子水中,视需要加入20g葡萄糖或等量的其它碳源,微温溶解,过滤除菌,2~8℃保存;产品规格:100g/瓶;产品用途:用于酵母杂交及遗传突变株的筛选和研究
马丁培养基;英文名称:Martin Medium;产品别名:马丁培养基基础;马丁培养基;使用说明:称取本品34.6g于1L蒸馏水或去离子水中,煮沸溶解1分钟,补水至1000ml,分装,121℃灭菌20分钟,灭菌结束后请摇匀以防琼脂沉底于底部而凝固,冷至55℃左右,备用;产品规格:250g/瓶;产品用途:用于真菌的培养,含琼脂、Cl霉素及孟加拉红
Wilkins-Chalgren厌氧菌肉汤培养基;英文名称:Wilkins-Chalgren Anaerobe Broth;产品别名:Wilkins-Chalgren厌氧菌肉汤培养基基础;Wilkins-Chalgren厌氧菌肉汤培养基;使用说明:称取本品33.0g于1L蒸馏水或去离子水中,加热煮沸至完全溶解,分装,121℃高压灭菌15分钟或115℃灭菌30分钟,冷却,备用;产品规格:250g/瓶;产品用途:用于厌氧菌的培养和药敏试验
改良DG-18琼脂培养基;英文名称:Dichloran Glycerol Agar Base,Modified;产品别名:改良DG-18琼脂培养基基础;改良DG-18琼脂培养基;使用说明:称取本品32.5g于1L蒸馏水或去离子水中,加热煮沸至完全溶解,加入220g,摇匀,分装,121℃高压灭菌15分钟,灭菌结束后请摇匀,以防琼脂沉积于器皿底部而凝固,备用;产品规格:250g/瓶;产品用途:用于霉菌酵母菌的计数,每升培养基中添加220g
Letheen琼脂培养基;英文名称:Letheen Agar Base;产品别名:Letheen琼脂培养基基础;Letheen琼脂培养基;使用说明:称取本品25.0g于1L蒸馏水或去离子,加热煮沸1分钟,分装,每100ml添加0.7g吐温80,121℃高压灭菌15分钟,倾注平板,备用;产品规格:250g/瓶;产品用途:用于化妆品卫生微生物检测,需添加7g/L吐温80
Amies运送培养基[含活性碳];英文名称:Amies Transport Medium with carbon;产品别名:Amies运送培养基基础[含活性碳];Amies运送培养基[含活性碳];使用说明:称取本品23.3g于1L蒸馏水或去离子水中,加热煮沸至完全溶解,搅拌分装,121℃高压灭菌15分钟,灭菌结束后冷至50-55℃左右轻轻摇匀以使活性炭均匀分布,立即至冷水中冷却,凝固,备用;产品规格:250g/瓶;产品用途:用于致病菌标本的采集、运输和保存
Schaedler肉汤培养基;英文名称:Schaedler Broth;产品别名:Schaedler肉汤培养基基础;Schaedler肉汤培养基;使用说明:称取本品28.4g于1L蒸馏水或去离子水中,微温溶解,分装,121℃高压灭菌15分钟,冷却,备用。如有需要,可选择性添加维生素K1,使用量为每升培养基添加1%的维生素K1乙醇溶夜1ml;产品规格:250g/瓶;产品用途:用于厌氧菌的增菌
Karmali氏弯曲杆菌琼脂培养基;英文名称:Karmali’s Campylobacter Medium;产品别名:Karmali氏弯曲杆菌琼脂培养基基础;Karmali氏弯曲杆菌琼脂培养基;使用说明:称取本品43.0g于1L蒸馏水或去离子水中,加热煮沸1分钟以上使彻底溶解,分装,121℃高灭菌15分钟,冷至50-55℃,无菌操作每100ml添加1支Karmali氏弯曲杆菌琼脂培养基添加剂,混匀,倾注平皿,备用;产品规格:500g/瓶;产品用途:用于弯曲菌的选择性分离培养,每100ml添加1支Karmali氏弯曲杆菌琼脂培养基添加剂
酵母安基酸缺陷型合成夜体培养基[亮安酸缺陷];英文名称:Yeast Synthetic Drop-out Fluid Medium without Leuc;产品别名:酵母安基酸缺陷型合成夜体培养基基础[亮安酸缺陷];酵母安基酸缺陷型合成夜体培养基[亮安酸缺陷];使用说明:称取本品8.32g溶于1000ml蒸馏水或去离子水中,视需要加入20g葡萄糖或等量的其它碳源,微温溶解,过滤除菌,2~8℃保存;产品规格:100g/瓶;产品用途:用于酵母杂交及遗传突变株的筛选和研究
Amies运送培养基[含活性碳];英文名称:Amies Transport Medium with carbon;产品别名:Amies运送培养基基础[含活性碳];Amies运送培养基[含活性碳];使用说明:称取本品23.3g于1L蒸馏水或去离子水中,加热煮沸至完全溶解,搅拌分装,121℃高压灭菌15分钟,灭菌结束后冷至50-55℃左右轻轻摇匀以使活性炭均匀分布,立即至冷水中冷却,凝固,备用;产品规格:250g/瓶;产品用途:用于致病菌标本的采集、运输和保存
光合细菌培养基Ⅰ;英文名称:Photosynthetic Bacteria Medium;产品别名:光合细菌培养基基础Ⅰ;光合细菌培养基Ⅰ;使用说明:称取本品6.8g于1L蒸馏水或去离子水中,煮沸溶解,分装,121℃高压灭菌30分钟。本品因含CaCl2而有稍许不溶物;产品规格:250g/瓶;产品用途:用于光合细菌的培养
乳酸菌Cl霉素琼脂培养基1;英文名称:Lactobacillus Chloramphenicol Agar 1;产品别名:乳酸菌Cl霉素琼脂培养基基础1;乳酸菌Cl霉素琼脂培养基1;使用说明:NULL;产品规格:500g/瓶;产品用途:用于干酪乳杆菌的培养
SCDLP琼脂培养基;英文名称:Soya Casein Digest Lecithin Polysorbate Agar Base;产品别名:SCDLP琼脂培养基基础;SCDLP琼脂培养基;使用说明:称取本品31.0g,另取吐温-80 7.0g,加热溶解于1000ml蒸馏水中,分装,121℃高压灭菌15分钟,备用;产品规格:250g/瓶;产品用途:用于化妆品细菌总数的测定,每升培养基添加1支吐温80
TGE琼脂培养基;英文名称:Tryptone Glucose Extract Agar;产品别名:TGE琼脂培养基基础;TGE琼脂培养基;使用说明:称取本品24.0g于1L蒸馏水或去离子水中,加热煮沸至完全溶解,分装,121℃高压灭菌15分钟,倾注平板,备用;产品规格:250g/瓶;产品用途:用于菌落总数测定
乙酰胺琼脂培养基;英文名称:Acetamide Agar;产品别名:乙酰胺琼脂培养基基础;乙酰胺培养基;乙酰胺琼脂培养基;使用说明:称取本品37.6g于1L蒸馏水或去离子水中,加热煮沸1分钟使完全溶解,分装,121℃高压灭菌20分钟,冷却,备用;产品规格:250g/瓶;产品用途:用于绿脓杆菌分离培养
缓冲MUG琼脂粉末培养基
抗生素培养基32号;英文名称:Medium 32;产品别名:抗生素培养基基础32号;抗生素培养基32号;使用说明:称取本品31.0g于1L蒸馏水或去离子水中(可按比例增加或减少配制量),加热煮沸至完全溶解,分装,121℃高压灭菌15分钟,冷却,备用;产品规格:250g/瓶;产品用途:用于微生物方法测定抗生素效价
Cl化钠多粘菌素B肉汤培养基;英文名称:Sodium Chloride Polymyxin Broth Base;产品别名:Cl化钠多粘菌素B肉汤培养基基础;SPB培养基;Cl化钠多粘菌素B肉汤培养基(SPB);使用说明:称取本品33克,加入1000ml蒸馏水中,混合后加热溶解,分装于三角瓶中,每瓶100ml,121℃15分钟高压灭菌,冷至50℃以下每100ml基础培养基中,加入1支多粘菌素B25000单位,混匀,无菌分装于灭菌试管;产品规格:250g/瓶;产品用途:用于副溶血性弧菌选择性增菌,每100ml添加1支多粘菌素B(2.5万单位)
精安酸双水解酶试验培养基;英文名称:Double-arginine Hydrolase Test Medium;产品别名:精安酸双水解酶试验培养基基础;精安酸脱羧酶肉汤;精安酸双水解酶试验培养基;使用说明:称取本品14.0g于1L蒸馏水或去离子水中,加热煮沸至完全溶解,分装试管,每支试管滴加高约0.3mm的左右的夜体石蜡,121℃高压灭菌15分钟或115℃灭菌30分钟,备用;产品规格:100g/瓶;产品用途:用于细菌的精安酸双水解酶试验
Aliz-gal琼脂培养基;英文名称:Aliz-gal Agar;产品别名:Aliz-gal琼脂培养基基础;Aliz-gal琼脂培养基;使用说明:称取本品46.7g于1L蒸馏水或去离子水中,加热煮沸至完全溶解,分装,116℃高压灭菌10分钟,灭菌结束后请摇匀,以防琼脂沉积于器皿底部而凝固,备用;产品规格:100g/瓶;产品用途:用于大肠菌群快速检测
麦康凯肉汤培养基;英文名称:MacConkey Broth;产品别名:麦康凯肉汤培养基基础;麦康凯肉汤培养基;使用说明:称取本品35.0g于1L蒸馏水或去离子水中(可按比例增加或减少配制量),微温溶解,分装,121℃灭菌15分钟,冷却,备用;产品规格:250g/瓶;产品用途:用于肠道菌选择性增菌
改良卵磷脂琼脂培养基;英文名称:Modified Letheen Agar Base;产品别名:改良卵磷脂琼脂培养基基础;改良卵磷脂琼脂培养基;使用说明:称取本品48.0g,加热溶解于1000ml蒸馏水中,分装,121℃高压灭菌20分钟,备用;产品规格:250g/瓶;产品用途:用于化妆品中菌落总数计数,每升培养基需添加7g吐温80
KM2猪肺炎支原体琼脂培养基;英文名称:KM2 Mycoplasma Hyopneumoniae Agar Medium;产品别名:KM2猪肺炎支原体琼脂培养基基础;KM2猪肺炎支原体琼脂培养基;使用说明:称取本品38.9g于800ml蒸馏水或去离子水中,煮沸溶解,115℃灭菌20分钟,冷至55℃左右,无菌操作加入0.125g无菌、20万单位无菌青霉素和200ml无菌健康猪血清,混匀,倾注平板,备用;产品规格:250g/瓶;产品用途:需添加马血清、青霉素和
"


![缓冲MUG琼脂培养基[源头供货]](https://img.chemicalbook.com/SupplyImg1/2025-01-22/Large/202501222123556546138.jpg)